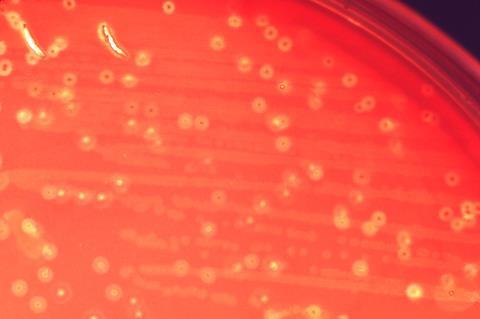

A recent study published in Cell Reports Medicine has identified distinct microbial “signatures” within the oral cavity and gut that serve as robust biomarkers for the early detection of gastric cancer (GC).
This collaborative research, conducted by BGI Genomics and by academician of the CAS, Fang Jingyuan, and his team at Renji Hospital, Shanghai Jiao Tong University School of Medicine, elucidates how specific lactic acid-producing bacteria (LAB) migrate from the mouth to colonize the gastrointestinal tract, fostering a pro-tumorigenic environment that accelerates malignancy. In a related study published in Gut, the same team demonstrated how Streptococcus anginosus (Sa) promotes gastric cancer via methionine metabolites.
Using high-precision metagenomic sequencing of 404 samples, researchers identified a significant taxonomic shift in the microbiomes of GC patients. The study identified 28 bacterial species with differential abundance, 23 of which were enriched in the GC cohort. Notably, 20 of these enriched species were “shared,” typically residing in the oral cavity but found thriving in the gut of cancer patients.
To confirm the origin of these microbes, researchers used population-average nucleotide identity (popANI) for strain-level genetic analysis. The results revealed that oral and gut strains within the same individual shared over 99.9% genetic similarity, providing definitive evidence of an oral-to-gut translocation. This finding effectively confirms a “migration” of bacteria from the mouth to the intestines.
Mechanisms of tumor promotion
Upon reaching the gut, these bacteria do not function in isolation. They establish a robust co-abundance network that enhances their resilience against harsh physiological barriers, such as gastric acid and bile salts. This microbial consortium drives a metabolic shift toward increased lactic acid fermentation, which significantly acidifies the tumor microenvironment.
This localized acidification triggers several critical oncogenic pathways, including the activation of matrix metalloproteinases that facilitate tissue remodeling, tumor invasion, and angiogenesis. Simultaneously, this environment promotes immune evasion by recruiting immunosuppressive cells, effectively creating a biological sanctuary that shields the developing tumor from the host’s immune response.
The “initiator-promoter” model
These findings support a revised ”’initiator-promoter” framework for gastric carcinogenesis, wherein Hp serves as the initiator by inducing chronic inflammation and compromising the stomach’s protective mucosal barrier.
Following this initial damage, oral lactic acid bacteria act as promoters, colonizing the weakened epithelium and fueling disease progression through biofilm formation and immune modulation.

This dual-action paradigm provides a crucial explanation for why gastric cancer can develop in Hp-negative patients and why a residual risk of malignancy often persists even after the successful eradication of the primary infection.
Clinical implications for non-invasive diagnostics
From a clinical standpoint, the study marks a significant advance in non-invasive screening. Researchers developed machine learning models based on these microbial markers, achieving an AUROC of 0.87 for saliva-based detection and 0.85 for stool-based detection.
Given that saliva collection is non-invasive and cost-effective, it presents a promising tool for large-scale early screening. Ultimately, this research reshapes our understanding of the microbiome’s systemic role in oncology and highlights the oral-gut axis as a primary target for future diagnostic and microbiome-based therapeutic interventions.







No comments yet